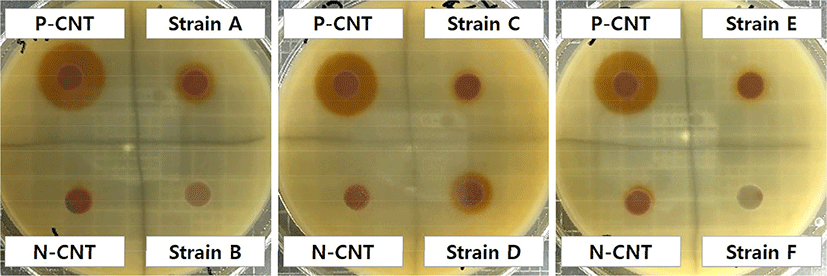

List of Articles
Food Science of Animal Resources. Vol. 41, No. 2, 2021
REVIEW

Clean Label Meat Technology: Pre-Converted Nitrite as a Natural Curing
Food Sci Anim Resour 2021;41(2):173-184.
https://doi.org/10.5851/kosfa.2020.e96
HTML
PDF
PubReader
Cited by 49
https://doi.org/10.5851/kosfa.2020.e96
ARTICLE

Effects of High Hydrostatic Pressure on Technical Functional Properties of Edible Insect Protein
Food Sci Anim Resour 2021;41(2):185-195.
https://doi.org/10.5851/kosfa.2020.e85
HTML
PDF
PubReader
Cited by 38
https://doi.org/10.5851/kosfa.2020.e85

Effects of Autochthonous Yeast Cultures on Some Quality Characteristics of Traditional Turkish Fermented Sausage “Sucuk”
Food Sci Anim Resour 2021;41(2):196-213.
https://doi.org/10.5851/kosfa.2020.e89
HTML
PDF
PubReader
Cited by 10
https://doi.org/10.5851/kosfa.2020.e89

Comparison of Quality Characteristics and Palatability between Sous-Vide Cooked Pork Loin Patties with Different Searing Treatments
Food Sci Anim Resour 2021;41(2):214-223.
https://doi.org/10.5851/kosfa.2020.e90
HTML
PDF
PubReader
Cited by 7
https://doi.org/10.5851/kosfa.2020.e90

Investigation of Physicochemical and Sensory Quality Differences in Pork Belly and Shoulder Butt Cuts with Different Quality Grades
Food Sci Anim Resour 2021;41(2):224-236.
https://doi.org/10.5851/kosfa.2020.e91
HTML
PDF
PubReader
Cited by 15
https://doi.org/10.5851/kosfa.2020.e91

Taste-Active and Nutritional Components of Thai Native Chicken Meat: A Perspective of Consumer Satisfaction
Food Sci Anim Resour 2021;41(2):237-246.
https://doi.org/10.5851/kosfa.2020.e94
HTML
PDF
PubReader
Cited by 32
https://doi.org/10.5851/kosfa.2020.e94

Quality Properties of Bulgogi Sauce with Crust Derived from Dry-Aged Beef Loin
Food Sci Anim Resour 2021;41(2):247-260.
https://doi.org/10.5851/kosfa.2020.e95
HTML
PDF
PubReader
Cited by 5
https://doi.org/10.5851/kosfa.2020.e95

Physicochemical Analysis of Yogurt Produced by Leuconostoc mesenteroides H40 and Its Effects on Oxidative Stress in Neuronal Cells
Food Sci Anim Resour 2021;41(2):261-273.
https://doi.org/10.5851/kosfa.2020.e97
HTML
PDF
PubReader
Cited by 18
https://doi.org/10.5851/kosfa.2020.e97

Physiological Characteristics and Anti-Diabetic Effect of Pediococcus pentosaceus KI62
Food Sci Anim Resour 2021;41(2):274-287.
https://doi.org/10.5851/kosfa.2020.e99
HTML
PDF
PubReader
Cited by 6
https://doi.org/10.5851/kosfa.2020.e99

Mathematical Models for the Biofilm Formation of Geobacillus and Anoxybacillus on Stainless Steel Surface in Whole Milk
Food Sci Anim Resour 2021;41(2):288-299.
https://doi.org/10.5851/kosfa.2020.e100
HTML
PDF
PubReader
Cited by 2
https://doi.org/10.5851/kosfa.2020.e100
Isolation of the Cholesterol-Assimilating Strain Pediococcus acidilactici LRCC5307 and Production of Low-Cholesterol Butter
Food Sci Anim Resour 2021;41(2):300-311.
https://doi.org/10.5851/kosfa.2020.e101
HTML
PDF
PubReader
Cited by 10
https://doi.org/10.5851/kosfa.2020.e101

Nuclear Magnetic Resonance (NMR)-Based Quantification on Flavor-Active and Bioactive Compounds and Application for Distinguishment of Chicken Breeds
Food Sci Anim Resour 2021;41(2):312-323.
https://doi.org/10.5851/kosfa.2020.e102
HTML
PDF
PubReader
Cited by 19
https://doi.org/10.5851/kosfa.2020.e102

High Prevalence of Listeria monocytogenes in Smoked Duck: Antibiotic and Heat Resistance, Virulence, and Genetics of the Isolates
Food Sci Anim Resour 2021;41(2):324-334.
https://doi.org/10.5851/kosfa.2021.e2
HTML
PDF
PubReader
Cited by 17
https://doi.org/10.5851/kosfa.2021.e2
SHORT COMMUNICATION

Development of Pretreatment Method for Analysis of Vitamin B12 in Cereal Infant Formula using Immunoaffinity Chromatography and High-Performance Liquid Chromatography
Food Sci Anim Resour 2021;41(2):335-342.
https://doi.org/10.5851/kosfa.2020.e92
HTML
PDF
PubReader
Cited by 2
https://doi.org/10.5851/kosfa.2020.e92

Prevention of Cholesterol Gallstone Formation by Lactobacillus acidophilus ATCC 43121 and Lactobacillus fermentum MF27 in Lithogenic Diet-Induced Mice
Food Sci Anim Resour 2021;41(2):343-352.
https://doi.org/10.5851/kosfa.2020.e93
HTML
PDF
PubReader
Cited by 17
https://doi.org/10.5851/kosfa.2020.e93
ERRATUM
Erratum to: Description of Kinetic Behavior of Pathogenic Escherichia coli in Cooked Pig Trotters under Dynamic Storage Conditions Using Mathematical Equations
Food Sci Anim Resour 2021;41(2):353
https://doi.org/10.5851/kosfa.2021.e6
HTML
PDF
PubReader
Cited by 0
https://doi.org/10.5851/kosfa.2021.e6